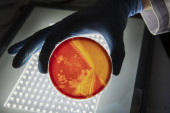

Hodowla bakterii w podłożu agarowym w laboratorium mikrobiologicznym. Dokonywanie smugi w szalce Petriego izolowane na białym tle. Mieszanina kolonii bakterii w szalce Petriego.

Informacje o pliku:
| Numer pliku: | 0101440100482 |
| Typ pliku/format: | Zdjęcia ( JPG ) |
| Rozdzielczość: | 4000x2667 (33,87x22,58 cm 300 dpi) |
| Kategorie: | |
| Autor: | mc.atolye |